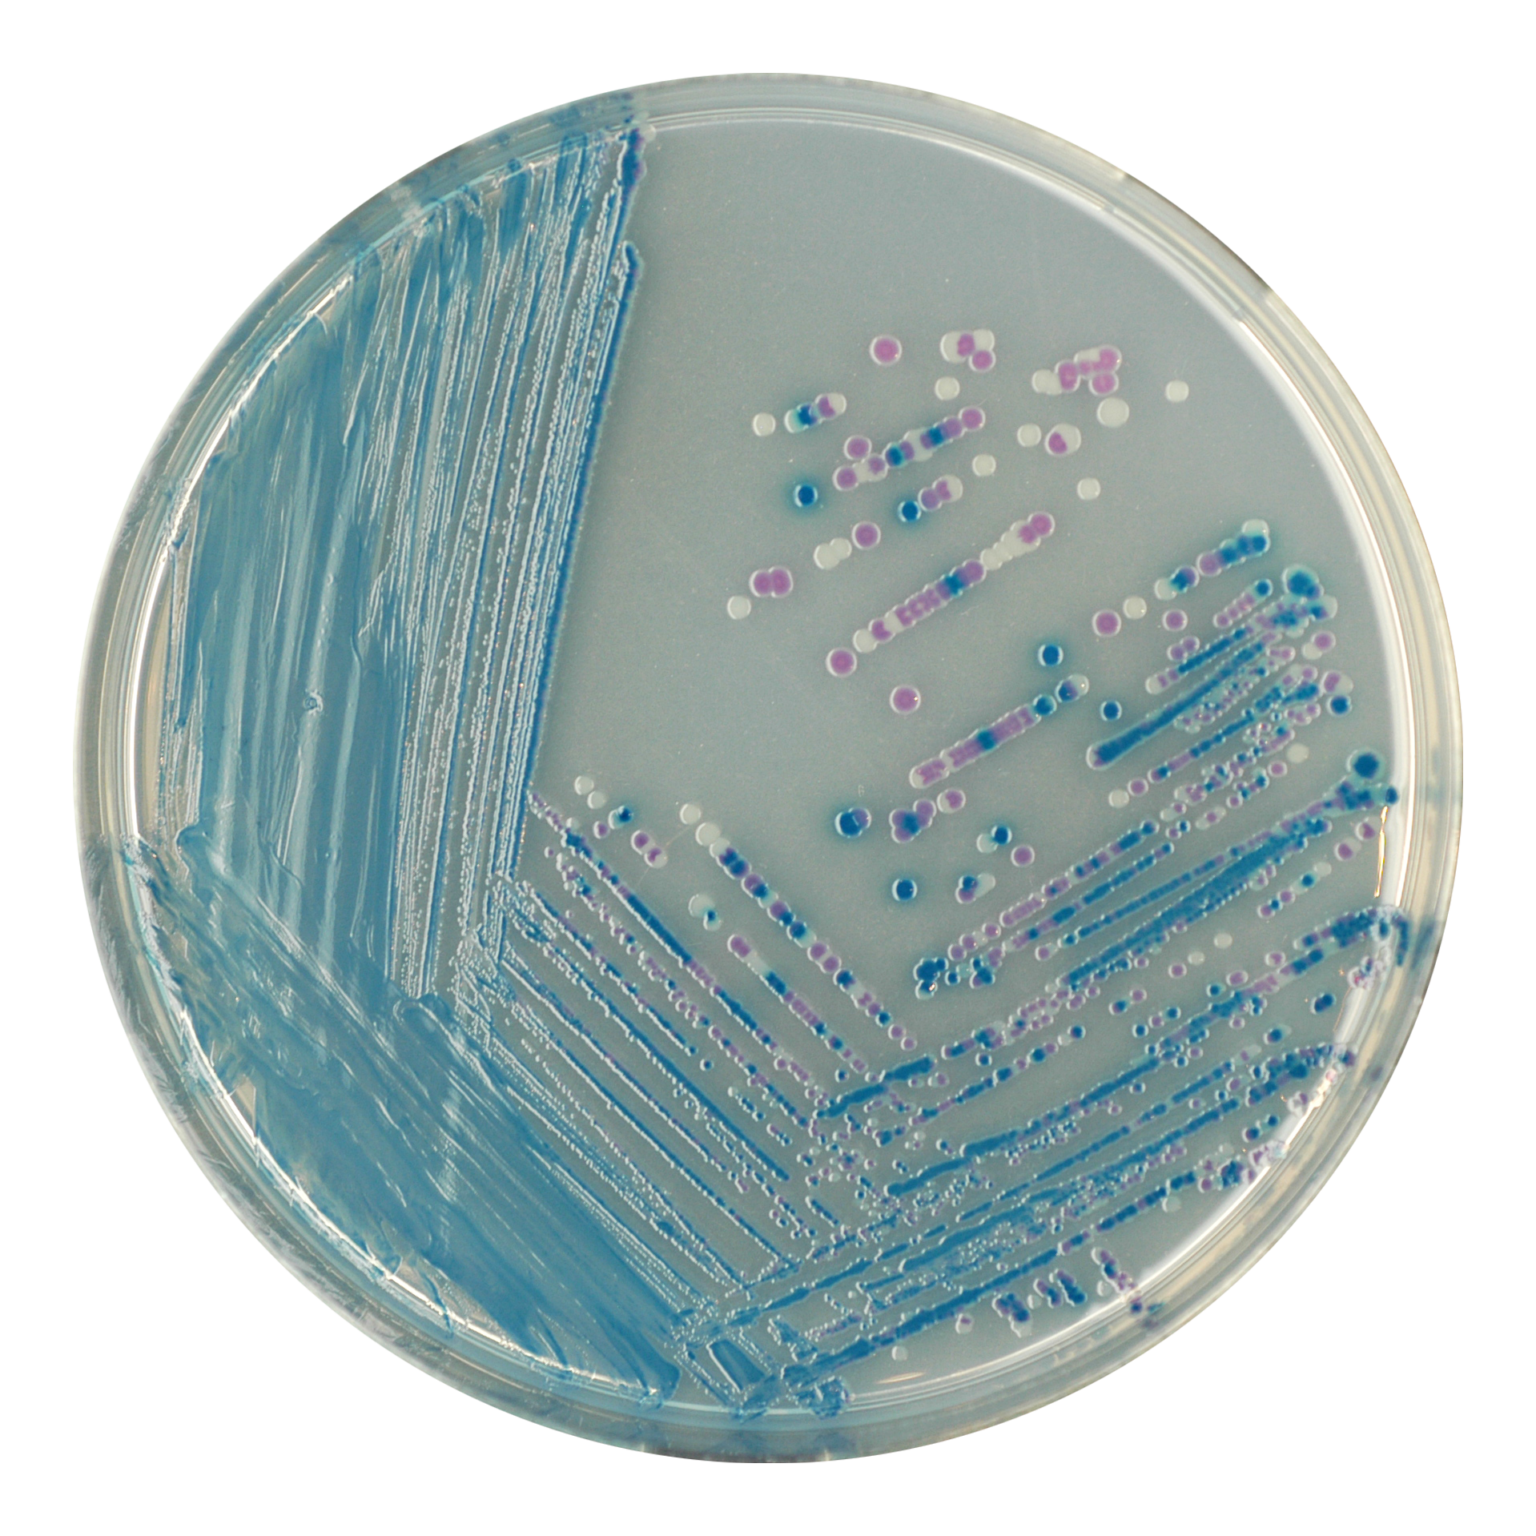

Giải pháp tối ưu hóa quy trình kiểm nghiệm vi sinh vật gây bệnh trong chuỗi cung ứng thực phẩm
- Giải Pháp Tối Ưu Hóa Quy Trình Kiểm Nghiệm Vi Sinh Vật Gây Bệnh Trong Chuỗi Cung Ứng Thực Phẩm
- 1. Bối cảnh an toàn thực phẩm và tính cấp thiết của công tác kiểm nghiệm
- 2. Điểm nghẽn của các phương pháp nuôi cấy truyền thống theo tiêu chuẩn ISO
- 3. Đột phá định danh với hệ thống môi trường sinh màu CHROMagar™
- 3.1. Tăng tốc phát hiện Salmonella với RambaQUICK và Salmonella Plus
- 3.2. Sàng lọc chính xác E. coli O157 và STEC
- 4. Khẳng định cấp độ phân tử bằng công nghệ Real-time PCR
- 5. Kết luận: Quy trình tích hợp Toàn Cầu – Tiêu chuẩn cho ATVSTP
An toàn thực phẩm (ATTP) là thách thức lớn, điển hình qua vụ ngộ độc Salmonella và E. coli tại Đắk Lắk. Phương pháp ISO truyền thống mất 4-6 ngày và thiếu độ chính xác với chủng biến thể (Lac+). Giải pháp Toàn Cầu tích hợp CHROMagar (rút ngắn tăng sinh Salmonella xuống 7 giờ) và Mic Real-time PCR (<25 phút khẳng định gen bằng công nghệ từ tính) giúp giảm TAT xuống 24-48 giờ, đảm bảo phân tích nhanh, chính xác mầm bệnh nguy hiểm.
Giải Pháp Tối Ưu Hóa Quy Trình Kiểm Nghiệm Vi Sinh Vật Gây Bệnh Trong Chuỗi Cung Ứng Thực Phẩm
1. Bối cảnh an toàn thực phẩm và tính cấp thiết của công tác kiểm nghiệm
An toàn vệ sinh thực phẩm (ATVSTP) hiện là thách thức y tế công cộng và quản lý chuỗi cung ứng tại Việt Nam. Các vụ ngộ độc tập thể không chỉ đe dọa tính mạng người tiêu dùng mà còn gây hệ lụy nặng nề về kinh tế và uy tín cho doanh nghiệp.
Sự cố ngộ độc hàng loạt tại Đắk Lắk vào cuối tháng 3/2026 khiến 86 người nhập viện sau khi ăn bánh mì là một hồi chuông cảnh báo. Kết quả từ Viện Vệ sinh Dịch tễ Tây Nguyên xác nhận sự hiện diện đồng thời của Salmonella (phát hiện trong dăm bông, rau sống và bệnh phẩm) và E. coli (trong mẫu rau). Sự lây nhiễm chéo này đòi hỏi các phương pháp kiểm nghiệm phải có độ nhạy, độ đặc hiệu cao và khả năng trả kết quả nhanh chóng để kịp thời cô lập nguồn lây.
Hình 1. Bác sĩ thăm khám bệnh nhân bị ngộ độc thực phẩm do Salmonella spp.
2. Điểm nghẽn của các phương pháp nuôi cấy truyền thống theo tiêu chuẩn ISO
Dù là phương pháp tham chiếu pháp lý, quy trình nuôi cấy truyền thống đang bộc lộ nhiều hạn chế về thời gian (TAT) và độ chính xác đối với các chủng biến dị.
-
Salmonella (ISO 6579-1:2017): Quy trình 4-5 ngày qua các bước tiền tăng sinh (BPW), tăng sinh chọn lọc (RV/MKTTn), phân lập trên thạch XLD và khẳng định sinh hóa/huyết thanh. Điểm yếu lớn nhất là các chủng Salmonella dương tính với lactose (Lac+) thường bị bỏ sót trên thạch truyền thống do có kiểu hình giống vi khuẩn vô hại (Coliforms), dẫn đến âm tính giả.
-
E. coli O157 (ISO 16654:2001): Yêu cầu kỹ thuật tách chiết miễn dịch từ tính (IMS) phức tạp và môi trường CT-SMAC thường cho kết quả dương tính giả cao từ Proteus hoặc E. hermanii.
-
STEC (ISO/TS 13136:2012): Dù sàng lọc nhanh bằng PCR, việc phân lập chủng thuần STEC từ dịch nền hỗn hợp gặp nhiều khó khăn do thiếu môi trường nuôi cấy có tính chọn lọc đủ mạnh.
Hình 2. Sơ đồ vắn tắt các bước quy trình kiểm nghiệm Salmonella theo ISO 6579-1:2017
Hình 3. Sơ đồ các bước quy trình kiểm nghiệm E. coli O157 theo tiêu chuẩn ISO 16654:2001 và ISO/TS 13136:2012 đối với E. coli STEC
3. Đột phá định danh với hệ thống môi trường sinh màu CHROMagar™
Nhằm khắc phục các hạn chế trên, Công ty TNHH Khoa học Kỹ thuật Toàn Cầu phân phối giải pháp môi trường sinh màu từ CHROMagar (Pháp), giúp nhận diện vi khuẩn dựa trên màu sắc khuẩn lạc đặc trưng.
3.1. Tăng tốc phát hiện Salmonella với RambaQUICK và Salmonella Plus
Sự kết hợp này mang lại hiệu suất vượt trội so với ISO truyền thống:
-
RambaQUICK™ Salmonella: Thay thế RV và MKTTn, rút ngắn chu kỳ tăng sinh chọn lọc xuống còn 7 giờ (thay vì 24 giờ), cho phép cấy đĩa ngay trong ngày đầu tiên.
-
CHROMagar™ Salmonella Plus: Môi trường sinh màu tiên tiến có khả năng phát hiện xuất sắc các chủng Lac+, S. typhi và S. paratyphi với màu tím hoa cà (mauve) đặc trưng. Độ nhạy và độ đặc hiệu đạt mức 99%, loại bỏ sự che lấp từ hệ vi khuẩn nền như E. coli (không màu) hay Coliforms (xanh lam).
Hình 4. Sơ đồ so sánh timeline quy trình kiểm Salmonella theo ISO và CHROMagar
3.2. Sàng lọc chính xác E. coli O157 và STEC
-
CHROMagar™ O157: Cho kết quả sau 24 giờ với khuẩn lạc màu tím, khắc phục tình trạng âm tính giả trên thạch SMAC và đạt độ nhạy 89% đối với EHEC O157.
-
CHROMagar™ STEC: Giải pháp tiên phong phát hiện cả O157 và nhóm "Top 5" serogroups (O26, O45, O103, O111, O145). Chỉ sau 18-24 giờ, các chủng STEC nguy hiểm sẽ xuất hiện với màu tím, cho phép định danh nhanh chóng và tương thích hoàn hảo với hệ thống MALDI-TOF MS.
Hình 5. Môi trường CHROMagar O157 (trái) và CHROMagar STEC (phải)
4. Khẳng định cấp độ phân tử bằng công nghệ Real-time PCR
Trong các tình huống khẩn cấp như vụ ngộ độc tại Đắk Lắk, kỹ thuật Real-time PCR là "chìa khóa" rút ngắn thời gian khẳng định từ vài ngày xuống dưới 1 giờ.
4.1. Hóa chất Mastermix qPCRBIO Probe Mix
Hóa chất từ PCRBio (Anh) được Công ty Toàn Cầu phân phối có các đặc tính ưu việt:
-
Độ nhạy cực cao: Hiệu quả ngay cả với các mẫu có số lượng bản sao thấp hoặc chứa nhiều chất ức chế từ thực phẩm.
-
Khả năng Multiplex: Phát hiện đồng thời DNA của Salmonella và các gen độc lực STEC (stx1, stx2, eae) trong cùng một ống phản ứng.
-
Separate-ROX: Linh hoạt, tương thích với mọi hệ thống máy luân nhiệt trên thị trường.
Hình 6. qPCRBIO Probe Mixes Seperate-ROX (PB20.24-01)
4.2. Thiết bị Mic Real-time PCR – Công nghệ cảm ứng từ
Thiết bị từ BMS (Úc) tái định nghĩa tốc độ và độ chính xác trong phòng thí nghiệm:
-
Tốc độ kỷ lục: Hoàn thành 35 chu trình PCR trong dưới 25 phút nhờ công nghệ cảm ứng từ tính (Magnetic Induction) sinh nhiệt trực tiếp trên rotor.
-
Độ đồng nhất tuyệt đối: Chênh lệch nhiệt độ giữa các giếng chỉ ± 0.05ºC, loại bỏ sai số do vị trí đặt mẫu và không cần hiệu chuẩn quang học.
-
Thiết kế thông minh: Trọng lượng 2.1 kg, kết nối Bluetooth, tích hợp lực ly tâm giúp quy trình vận hành đơn giản và di động.
Hình 7. Máy real-time PCR từ tính - Mic
5. Kết luận: Quy trình tích hợp Toàn Cầu – Tiêu chuẩn cho ATVSTP
Việc chuyển dịch từ quy trình ISO cổ điển sang mô hình "Sàng lọc và Khẳng định nhanh" giúp giảm TAT trung bình từ 4 - 6 ngày xuống chỉ còn 24 - 48 giờ.
Hệ sinh thái giải pháp từ Công ty TNHH Khoa học Kỹ thuật Toàn Cầu — bao gồm môi trường CHROMagar, máy Mic PCR và hóa chất PCRBio — không chỉ tối ưu hóa năng suất phòng thí nghiệm mà còn xây dựng lá chắn bảo vệ sức khỏe cộng đồng vững chắc trước các mầm bệnh biến đổi phức tạp.
|
Đặc điểm quy trình |
Phương pháp ISO truyền thống |
Giải pháp tích hợp Toàn Cầu |
|
Thời gian tăng sinh |
42 giờ (2 bước) |
7 giờ (RambaQUICK) |
|
Độ chính xác phân lập |
Dễ âm tính giả (Salmonella Lac+) |
Trực quan, độ nhạy 99% (CHROMagar) |
|
Khẳng định kết quả |
48-72 giờ (Sinh hóa/Huyết thanh) |
< 25 phút (Mic Real-time PCR) |
|
Tổng thời gian (TAT) |
4 - 6 ngày |
24 - 48 giờ |
Nguồn trích dẫn chính:
-
[1] VnExpress/ANTV/Suckhoedoisong: Vụ ngộ độc bánh mì tại Đắk Lắk (04/2026).
-
[2] Tiêu chuẩn ISO 6579-1:2017, ISO 16654:2001, ISO/TS 13136:2012.
-
[3] Tài liệu kỹ thuật CHROMagar, PCR Biosystems và Biomolecular Systems.

CÔNG TY TNHH KHOA HỌC KỸ THUẬT TOÀN CẦU
Trụ sở: Lầu 19, khu A, số 4 Nguyễn Đình Chiểu, Phường Đa Kao, Quận 1, TP. Hồ Chí Minh, Việt Nam
VP HCM: 48 Châu Thị Hóa, Phường 4, Quận 8, TP. Hồ Chí Minh
VP HN: Số nhà 59B ngõ 148 Trần Duy Hưng, phường Trung Hòa, Quận Cầu Giấy, Hà Nội
Hotline: 0908.090.555
Email: dinh@global.net.vn
Website: https://globallab.com.vn/

Xem thêm